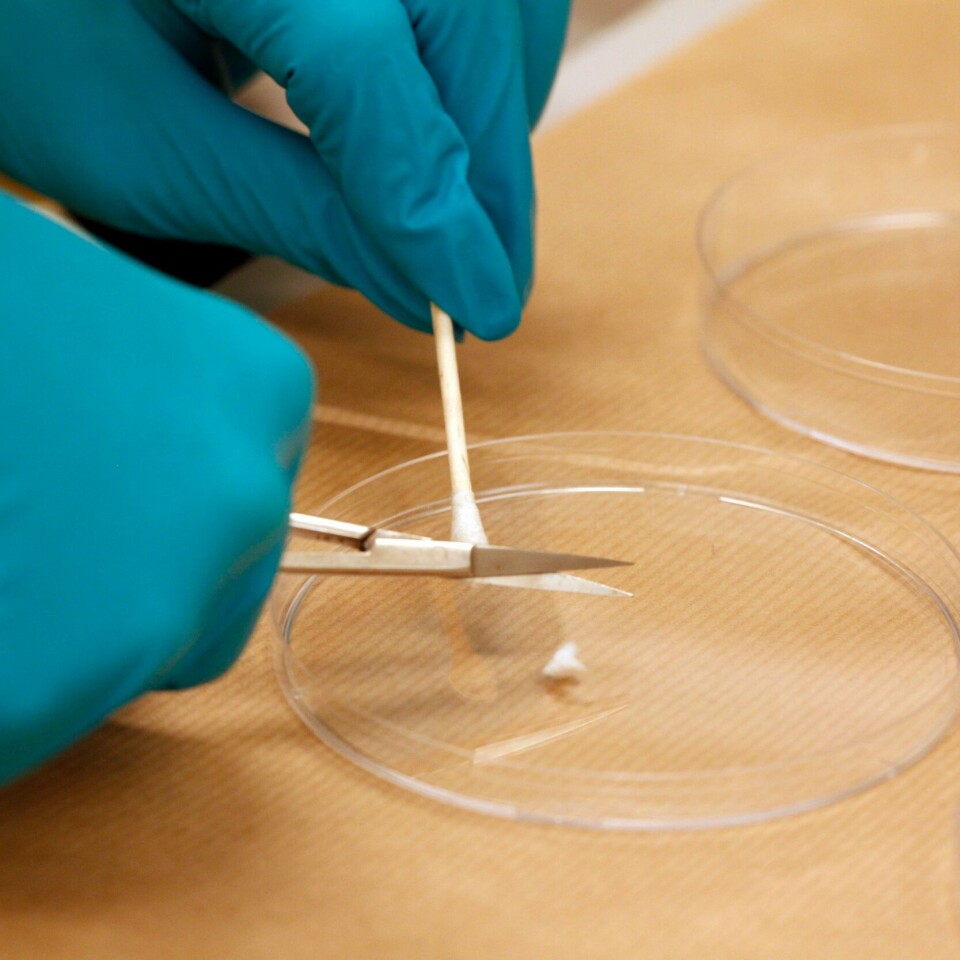
UNDERSØKELSER: Nye undersøkelser av arvematerialet DNA i eldre kriminalsaker, har allerede fått følger. Hva som blir resultatet i Birgitte Tengs-saken, er fortsatt uavklart. Bildet viser undersøkelser av biologisk materiale. Illustrasjonsfoto: Lise Åserud / NTB

Leder
Ny teknologi kan avsløre flere hemmeligheter
Nye undersøkelser med nye metoder gir gjennombrudd i flere kriminalsaker. Kanskje blir flere hemmeligheter avslørt i tida framover?
Dette er en leder. En leder er en kommentar som gir uttrykk for hva avisen mener.
En 26 år gammel drapssak kan få en løsning. Takket være nye metoder å etterforske på. Nyheten i Birgitte Tengs-saken rystet Norge fredag. En ny siktet i et drap med ukjent gjerningsmann. Personen er også mistenkt for et annet drap.
Politet lener seg på det de kaller tekniske bevis, DNA. Nye analyser kan ha avslørt hvem som drepte jenta på Karmøy i 1995.
DNA er vårt arvestoff, vår unike kode. Med årene har forskere blitt stadig bedre på å finne ut av hvordan vi er satt sammen. Dette DNA-et kan også plukkes fra hverandre i små biter. Sammensetningen kan avsløre hver og en av oss. Derfor blir det et stadig mer presist verktøy i kriminalsaker.
DNA kan ikke alene avsløre om noen er skyldig i et drap. Men det er en viktig brikke i puslespillet som etterforskerne legger for å løse vanskelige saker. Sjekk av DNA er også en av årsakene til at drapsdømte Viggo Kristiansen får saken sin vurdert på nytt.
Dermed kan det komme flere hemmeligheter fram i tida som kommer. Det finnes fortsatt flere både uløste og løste alvorlige kriminalsaker i Norge. Kanskje kan DNA og teknologi avsløre en ny sannhet i noen av dem.












